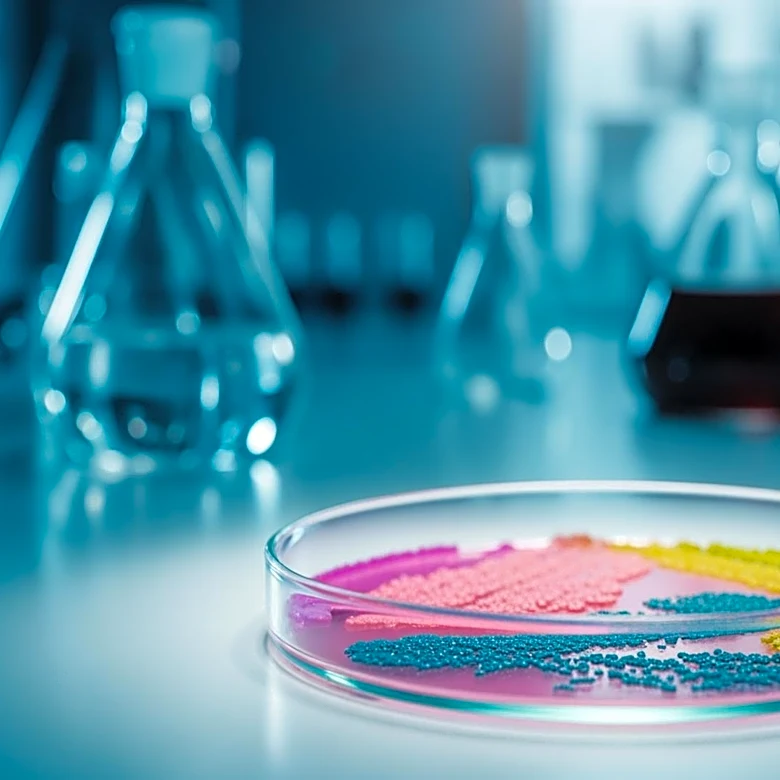
Vedanta Biosciences Presents Microbiome-Based Therapeutics at ESCMID Congress

What's Happening?
Researchers from the University of São Paulo and the University of Auckland have identified the lateral parafacial (pFL) brain region as a potential contributor to high blood pressure. The study suggests that the pFL region, which is linked to breathing
control, can also tighten blood vessels, potentially driving hypertension. This discovery could explain why many individuals have uncontrolled blood pressure despite medication. The researchers used genetic engineering techniques on rats to observe the effects of activating pFL neurons, which led to increased blood pressure. The study highlights the need for new treatment options targeting the pFL neurons to manage hypertension effectively.
Why It's Important?
The findings of this study offer a new perspective on the causes of hypertension, a condition affecting a significant portion of the global population. By identifying a specific brain region involved in blood pressure regulation, the research opens up potential pathways for developing targeted treatments. This is particularly important as hypertension is a major risk factor for heart disease and other health conditions. The study's insights could lead to more effective management strategies for patients who do not respond well to current medications, ultimately improving health outcomes and reducing the burden of hypertension-related diseases.
What's Next?
The next steps involve developing drugs that can specifically target the pFL neurons without affecting other brain functions. Researchers are exploring the use of carotid body sensors to influence pFL neurons from outside the brain, offering a potential treatment pathway. This approach will require extensive testing to ensure safety and efficacy. If successful, it could provide a new therapeutic strategy for managing high blood pressure, particularly for patients with neurogenic components of hypertension.